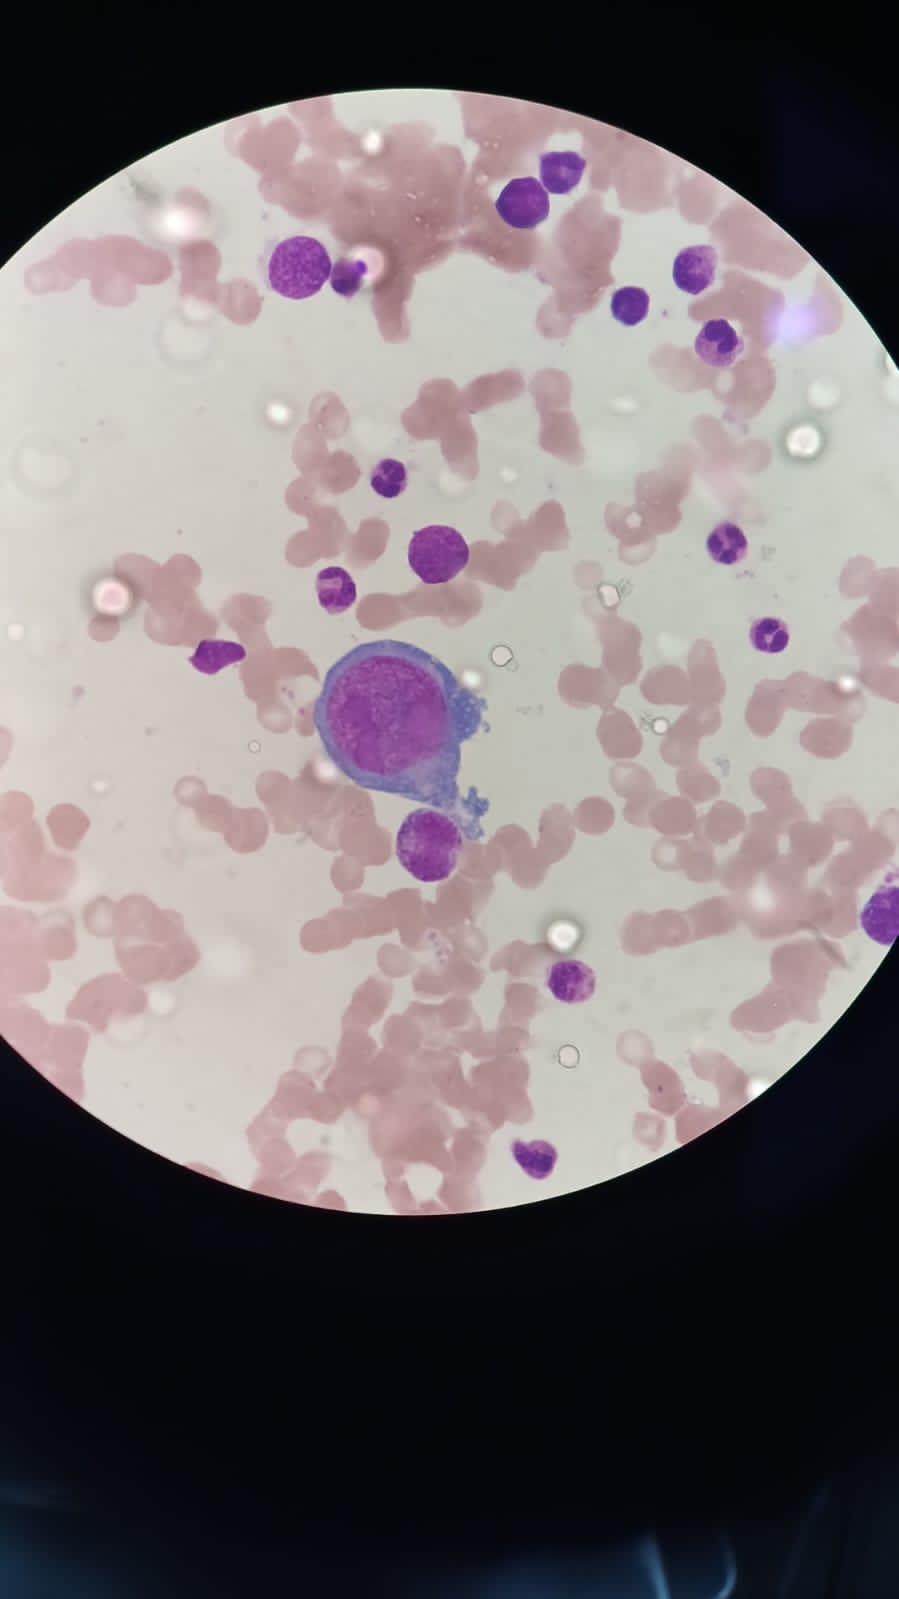

Human parvovirus B19 infection in kidney transplant recipients: Therapeutic strategies and outcomes
Arun Panjathia1, Ashish Sharma1, Deepesh B Kanwar1, Sarabpreet Singh1, Shiv Kumar Patil1, Amit Sharma1, Priscilla Rupali1.
1Renal and pancreas transplant department, post graduate institute of medical education and research, chandigarh, India
Introduction: Parvovirus is the member of parvoviridae family and belong to erythrovirus genus, name itself describes the affinity for erythroid progenitor cells. Persistence of B19V in immunosuppressed patients is due to inability to mount the humoral and cellular response and later on leads to severe anaemia that may require multiple blood transfusions and chronic pure red cell aplasia in kidney transplant patients.
Methods: PVB19 disease defined as PVB19 infection in patients with anaemia with clinical findings and bone marrow findings are consistent with diagnosis. Progressive severe anaemia with low reticulocytes count excluding hematopoietic inhibition were considered for DNA PCR testing. A total of Eight KTRs with allograft dysfunction and severe anaemia were detected by RTPCR to have PV-B19 in the 30-72 days of post-transplant period. KTRs baseline characteristics, therapeutic approaches, graft and patient outcomes were studied.
Results: A total of 8 patients were diagnosed with PVB19 infection in the first month of kidney transplantation. 6 out 8 patients were male, mean age of 33.8+/- 8.3 years.

Illustrative case: A 47 years male underwent Live renal allograft transplant. Received Induction immunosuppression with ATG with methylprednisolone and maintenance with Tac, MMF and prednisolone. In the first month of transplant, he had progressive decrease in Haemoglobin with low reticulocytes counts and with associated leukopenia, Immunosuppression interrupted and even after multiple blood transfusions he had refractory anaemia, Bone marrow biopsy revealed Pure Red cell aplasia with giant Pronormoblast cells containing viral inclusions consistent with parvo virus.
Viral load at the time of diagnosis 2.62*109, even after induction therapy of IVIG, viral load increased to 4.65*1012. Received total of three IVIG therapies five days each duration (cumulative dose 250gm) with persistent falling haemoglobin and low reticulocyte counts but ongoing graft dysfunction. Positive response seen with Foscarnet given for 5 days (60mg/kg/bd), viral load decreased to 3500 copies/ml. Immunosuppression interrupted for 2 months, haemoglobin normalises after therapy and MMF restarted again at low dose (500mg bd) and increased later on.
Summary of 8 cases: In addition to illustrative case 7 other cases with PVB19 infection were seen. Eight cases affected with kidney transplant (one with pancreas) recipient. Anaemia is observed in all the patients lowest hb 4.0 leukopenia seen in only one patient (table 1).
Conclusion: Early diagnosis and reduction of immunosuppression with or without IVIG therapy is the key to success for managing KTRs with parvo B19 infection, Foscarnet therapy is Safe, effective and alternative therapy to IVIG resistant cases but cost is the limiting factor. Multicentre studies are needed to define the optimal schedule for foscarnet therapy and for IVIG dose with duration and upto what time we should interrupt the immunosuppression is still a grey area.
